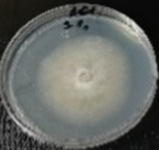
Molecules 26 04595 i001 Molecules 26 04595 i001
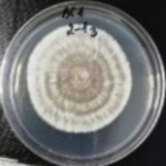
Molecules 26 04595 i002 Molecules 26 04595 i002
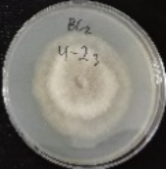
Molecules 26 04595 i006 Molecules 26 04595 i006
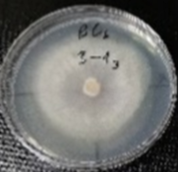
Molecules 26 04595 i016 Molecules 26 04595 i016
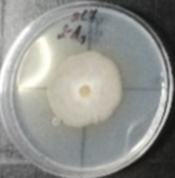
Molecules 26 04595 i020 Molecules 26 04595 i020
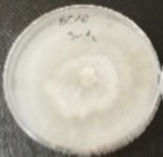
Molecules 26 04595 i028 Molecules 26 04595 i028
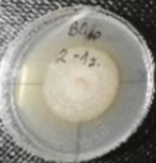
Molecules 26 04595 i029 Molecules 26 04595 i029

Sensitivity of Botrytis cinerea Isolates Complex to Plant Extracts
Abstract
1. Introduction
2. Results
2.1. Sensitivity of B. cinerea Isolates Complex to Plant Extracts
2.2. Morphological Attributes of the Isolates
3. Discussion
4. Materials and Methods
4.1. Botrytis Cinerea Isolates Complex
4.2. Plant Extracts
4.3. Determination of the Sensitivity to the Extracts
4.4. Examination of Morphological Attributes of the Isolates Complex
4.5. Statistical Analysis
5. Conclusions
Author Contributions
Funding
Acknowledgments
Conflicts of Interest
References
- Soylu, E.M.; Kurt, Ş.; Soylu, S. In vitro and in vivo antifungal activities of the essential oils of various plants against tomato grey mould disease agent Botrytis cinerea. Int. J. Food Microbiol. 2010, 143, 183–189. [Google Scholar] [CrossRef] [PubMed]
- Dammak, I.; Hamdi, Z.; El Euch, S.K.; Zemni, H.; Mliki, A.; Hassouna, M.; Lasram, S. Evaluation of antifungal and anti-ochratoxigenic activities of Salvia officinalis, Lavandula dentata and Laurus nobilis essential oils and a major monoterpene constituent 1,8-cineole against Aspergillus carbonarius. Ind. Crops Prod. 2019, 128, 85–93. [Google Scholar] [CrossRef]
- Saito, S.; Xiao, C.L. Fungicide resistance in Botrytis cinerea populations in California and its influence on control of gray mold on stored mandarin fruit. Plant. Dis. 2018, 102, 2545–2549. [Google Scholar] [CrossRef] [PubMed]
- Abbey, J.A.; Percival, D.; Abbey, L.; Asiedu, S.K.; Prithiviraj, B.; Schilder, A. Biofungicides as alternative to synthetic fungicide control of grey mould (Botrytis cinerea)–prospects and challenges. Biocontrol Sci. Technol. 2018, 29, 207–228. [Google Scholar] [CrossRef]
- Fontana, D.C.; Neto, D.D.; Pretto, M.M.; Mariotto, A.B.; Caron, B.O.; Kulczynski, S.M.; Schmidt, D. Using essential oils to control diseases in strawberries and peaches. Int. J. Food Microbiol. 2021, 338, 108980. [Google Scholar] [CrossRef]
- He, L.; Liu, Y.; Mustapha, A.; Lin, M. Antifungal activity of zinc oxide nanoparticles against Botrytis cinerea and Penicillium expansum. Microbiol. Res. 2011, 166, 207–215. [Google Scholar] [CrossRef] [PubMed]
- Morcia, C.; Malnati, M.; Terzi, V. In vitro antifungal activity of terpinen-4-ol, eugenol, carvone, 1,8-cineole (eucalyptol) and thymol against mycotoxigenic plant pathogens. Food Addit. Contam. Part A 2012, 29, 415–422. [Google Scholar] [CrossRef][Green Version]
- Wahab, H.A.; Malek, A.; Ghobara, M. Effects of some plant extracts, bioagents, and organic compounds on Botrytis and Sclerotinia molds. Acta Agrobot. 2020, 73, 7321. [Google Scholar] [CrossRef]
- Oliveira, M.S.; Costa, W.A.; Pereira, D.S.; Botelho, J.R.S.; Menezes, T.O.A.; Andrade, E.H.A.; Silva, S.H.M.; Filho, A.P.S.S.; Carvalho Junior, R.N. Chemical composition and phytotoxic activity of clove (Syzygium aromaticum) essential oil obtained with supercritical CO2. J. Supercrit. Fluids 2016, 118, 185–193. [Google Scholar] [CrossRef]
- De Oliveira Filho, J.G.; da Cruz Silva, G.; de Aguiar, A.C.; Cipriano, L.; de Azeredo, H.M.C.; Bogusz Junior, S.; Ferreira, M.D. Chemical composition and antifungal activity of essential oils and their combinations against Botrytis cinerea in strawberries. J. Food Meas. Charact. 2021, 15, 1815–1825. [Google Scholar] [CrossRef]
- Da Silva, P.P.M.; de Oliveira, J.; dos Biazotto, A.M.; Parisi, M.M.; da Glória, E.M.; Spoto, M.H.F. Essential oils from Eucalyptus staigeriana F. Muell. ex Bailey and Eucalyptus urograndis W. Hill ex Maiden associated to carboxymethylcellulose coating for the control of Botrytis cinerea Pers. Fr. and Rhizopus stolonifer (Ehrenb.:Fr.) Vuill. in strawberr. Ind. Crops Prod. 2020, 156, 112884. [Google Scholar] [CrossRef]
- Pinto, L.; Bonifacio, M.A.; De Giglio, E.; Cometa, S.; Logrieco, A.F.; Baruzzi, F. Unravelling the antifungal effect of red thyme oil (Thymus vulgaris L.) compounds in vapor phase. Molecules 2020, 25, 4761. [Google Scholar] [CrossRef] [PubMed]
- Packiam, S.M. Green Pesticides: Eco-friendly Technology for Integrated Pest Management. Acta Sci. Agric. 2018, 2, 1. [Google Scholar]
- De Corato, U.; Maccioni, O.; Trupo, M.; Di Sanzo, G. Use of essential oil of Laurus nobilis obtained by means of a supercritical carbon dioxide technique against post harvest spoilage fungi. Crop. Prot. 2010, 29, 142–147. [Google Scholar] [CrossRef]
- Davari, M.; Ezazi, R. Chemical composition and antifungal activity of the essential oil of Zhumeria majdae, Heracleum persicum and Eucalyptus sp. against some important phytopathogenic fungi. J. Mycol. Med. 2017, 27, 463–468. [Google Scholar] [CrossRef]
- Youssef, K.; Roberto, S.R.; de Oliveira, A.G. Ultra-structural alterations in Botrytis cinerea—the causal agent of gray mold—treated with salt solutions. Biomolecules 2019, 9, 582. [Google Scholar] [CrossRef]
- Meng, L.; Mestdagh, H.; Ameye, M.; Audenaert, K.; Höfte, M.; Van Labeke, M.C. Phenotypic Variation of Botrytis cinerea Isolates Is Influenced by Spectral Light Quality. Front. Plant. Sci. 2020, 11, 1233. [Google Scholar] [CrossRef]
- Yusoff, S.F.; Haron, F.F.; Mohamed, M.T.M.; Asib, N.; Sakimin, S.Z.; Kassim, F.A.; Ismail, S.I. Antifungal activity and phytochemical screening of Vernonia amygdalina extract against Botrytis cinerea causing gray mold disease on tomato fruits. Biology 2020, 9, 286. [Google Scholar] [CrossRef]
- Wang, C.; Zhang, J.; Chen, H.; Fan, Y.; Shi, Z. Antifungal activity of eugenol against Botrytis cinerea. Trop. Plant. Pathol. 2010, 35, 137–143. [Google Scholar] [CrossRef]
- Veloukas, T.; Leroch, M.; Hahn, M.; Karaoglanidis, G.S. Detection and molecular characterization of boscalid-resistant Botrytis cinerea isolates from strawberry. Plant. Dis. 2011, 95, 1302–1307. [Google Scholar] [CrossRef]
- Cosseboom, S.D.; Schnabel, G.; Hu, M. Competitive ability of multi-fungicide resistant Botrytis cinerea in a blackberry planting over three years. Pestic. Biochem. Physiol. 2020, 163, 1–7. [Google Scholar] [CrossRef]
- Nielsen, B.J.; Jensen, N.L.; Hartvig, P.; Hjelmroth, L.; Weber, R.W.S. Fungicide Resistance in Botrytis in Danish Strawberry Production. Erwerbs-Obstbau 2021, 63, 1–6. [Google Scholar] [CrossRef]
- Fournier, E.; Giraud, T. Sympatric genetic differentiation of a generalist pathogenic fungus, Botrytis cinerea, on two different host plants, grapevine and bramble. J. Evol. Biol. 2008, 21, 122–132. [Google Scholar] [CrossRef] [PubMed]
- Rasiukevičiutė, N.; Moročko-Bičevska, I.; Sasnauskas, A. Characterisation of growth variability and mycelial compatibility of Botrytis cinerea isolates originated from apple and strawberry in Lithuania. Proc. Latv. Acad. Sci. Sect. B 2017, 71, 217–224. [Google Scholar] [CrossRef]
- Azevedo, D.M.Q.; Martins, S.D.S.; Guterres, D.C.; Martins, M.D.; Araújo, L.; Guimarães, L.M.S.; Alfenas, A.C.; Furtado, G.Q. Diversity, prevalence and phylogenetic positioning of Botrytis species in Brazil. Fungal Biol. 2020, 124, 940–957. [Google Scholar] [CrossRef] [PubMed]
- Kumari, S.; Tayal, P.; Sharma, E.; Kapoor, R. Analyses of genetic and pathogenic variability among Botrytis cinerea isolates. Microbiol. Res. 2014, 169, 862–872. [Google Scholar] [CrossRef]
- Rasiukevičiūtė, N.; Rugienius, R.; Šikšnianienė, J.B. Genetic diversity of Botrytis cinerea from strawberry in Lithuania. Zemdirbyste-Agriculture 2018, 105, 265–270. [Google Scholar] [CrossRef]
- Šernaitė, L.; Rasiukevičiūtė, N.; Dambrauskienė, E.; Viškelis, P.; Valiuškaitė, A. Biocontrol of strawberry pathogen Botrytis cinerea using plant extracts and essential oils. Zemdirbyste-Agriculture 2020, 107, 147–152. [Google Scholar] [CrossRef]
- Šernaitė, L.; Rasiukevičiūtė, N.; Valiuškaitė, A. The extracts of cinnamon and clove as potential biofungicides against strawberry grey mould. Plants 2020, 9, 613. [Google Scholar] [CrossRef]
- Šernaitė, L.; Rasiukevičiūtė, N.; Valiuškaitė, A. Application of plants extracts to control postharvest gray mold and susceptibility of apple fruits to B. cinerea from different plant hosts. Foods 2020, 9, 1430. [Google Scholar] [CrossRef]




| Extract | µL/L | BC1 | BC2 | BC3 | BC4 | BC5 | BC6 | BC7 | BC8 | BC9 | BC10 |
|---|---|---|---|---|---|---|---|---|---|---|---|
| Cinnamon | 100 | 7.80a | 7.80a | 7.80a | 7.80a | 7.80a | 7.80a | 7.80a | 7.80a | 7.80a | 7.80a |
| 200 | 7.80a | 7.80a | 7.71a | 7.80a | 7.80a | 7.80a | 7.80a | 7.80a | 7.80a | 7.54ba | |
| 300 | 0.58g | 7.80a | 7.80a | 7.80a | 7.80a | dgfe | 7.80a | 7.80a | 7.80a | 7.45ba | |
| 400 | 0.75g | 7.80a | 7.73a | 6.61ba | 7.76a | 6.63ba | 7.80a | 7.80a | 7.62a | 6.55b | |
| 500 | 0.00g | 4.80dc | 5.19c | 0.86g | 0.80i | 0.00i | 2.26f | 0.70i | 1.06fe | 1.76jhi | |
| 600 | 0.00g | 0.00g | 0.00e | 0.00g | 0.00i | 0.00i | 0.00g | 0.00i | 0.00f | 0.00k | |
| 800 | 0.00g | 0.00g | 0.00e | 0.00g | 0.00i | 0.00i | 0.00g | 0.00i | 0.00f | 0.00k | |
| Clove | 100 | 7.80a | 7.80a | 7.80a | 7.08ba | 7.80a | 7.80a | 7.80a | 7.80a | 7.80a | 6.69b |
| 200 | 7.14a | 6.30b | 6.96ba | 6.91ba | 6.01b | 7.08ba | 7.13a | 6.91b | 5.48cb | 4.41dc | |
| 300 | 5.29b | 4.56dce | 5.35c | 6.90ba | 4.79ed | 3.50dfe | 5.61cb | 6.19cb | 4.29cd | 3.56dfe | |
| 400 | 5.25b | 4.08dce | 3.05d | 4.38dce | 3.68fg | 5.25bc | 3.70e | 4.35fg | 3.63d | 3.87dce | |
| 500 | 0.00g | 2.58f | 0.00e | 2.83f | 3.28g | 0.00i | 4.55ced | 3.71g | 2.14e | 2.45ghf | |
| 600 | 0.00g | 0.02g | 1.22e | 1.29g | 2.24h | 1.61hgi | 1.44f | 2.01h | 1.77e | 1.38ji | |
| 800 | 0.00g | 0.00g | 0.00e | 0.00g | 0.00i | 0.99hi | 0.00g | 0.00i | 0.13f | 0.91jk | |
| Laurel | 2600 | 4.68cbd | 4.56dce | 6.93ba | 6.63ba | 5.30cbd | 6.65ba | 4.75cbd | 5.93cd | 5.61b | 4.78c |
| 2800 | 2.91efd | 4.38dce | 6.42bac | 4.95dc | 5.80cb | 6.18ba | 5.08cbd | 5.77cde | 5.27cb | 4.43dc | |
| 3000 | 3.08cefd | 3.90dfce | 5.30c | 4.48dce | 4.74ed | 5.54bc | 4.61ced | 4.98fe | 4.30cd | 3.84dce | |
| 3200 | 4.89cb | 3.29dfe | 6.58bac | 3.49fe | 5.10cd | 2.81dgfe | 4.66ced | 4.93fe | 4.79cbd | 2.95gfe | |
| 3400 | 1.93gef | 4.80dc | 5.25c | 4.86dce | 5.51cbd | 5.59bc | 5.29cb | 5.08fde | 5.65b | 2.99gfe | |
| 3600 | 1.44gf | 3.08fe | 5.98bc | 4.75dce | 4.24fe | 2.11hgfe | 5.77b | 4.45fg | 4.81cbd | 2.24ghi | |
| 3800 | 1.46gf | 3.25fe | 5.19c | 4.80dce | 4.06feg | 3.86dce | 5.01cbd | 5.07fde | 4.85cbd | 3.11gfe | |
| 4000 | 0.79g | 4.08dce | 5.10c | 3.99dfe | 3.83fg | 1.84hgf | 4.14ed | 4.59f | 4.51cbd | 2.73ghfe | |
| 4200 | 3.41cebd | 4.84c | 3.51d | 5.74bc | 5.45cbd | 4.35dc | 5.58cb | 5.76cde | 4.89cbd | 3.86dce |
| Isolate | Cinnamon Extract | Clove Extract | Laurel Extract | ||||||
|---|---|---|---|---|---|---|---|---|---|
| M | C | CM | M | C | CM | M | C | CM | |
| BC1 | − | − | | + | + | | + | − |  |
| BC2 | − | − |  | + | − |  | − | − | |
| BC3 | + | − |  | + | − |  | + | − |  |
| BC4 | − | − |  | + | − |  | + | − |  |
| BC5 | − | + |  | + | + |  | + | + |  |
| BC6 | − | − | | − | − |  | − | − |  |
| BC7 | + | + |  | + | + | | + | + |  |
| BC8 | + | − |  | − | − |  | + | + |  |
| BC9 | − | − |  | + | − |  | + | + |  |
| BC10 | − | + | | − | − | | + | − |  |
| Extract Isolate | Control | Cinnamon | Clove | Laurel | |||||
|---|---|---|---|---|---|---|---|---|---|
| 0 µL/L | 400 µL/L | 600 µL/L | 400 µL/L | 600 µL/L | 2600 µL/L | 2800 µL/L | 3000 µL/L | ||
| BC2 | Length | 19.38a | 18.93a | – | 13.56b | – | 14.82b | n.d. | 19.60a |
| Width | 14.54ba | 16.05a | 11.87b | 12.56b | 15.72a | ||||
| BC3 | Length | n.d. | 19.91a | n.d. | 19.07a | n.d. | |||
| Width | 16.05a | 12.34b | |||||||
| BC4 | Length | 19.92dc | 22.13a | 19.00ed | 20.30bdc | 21.02bac | 17.66e | 21.76ba | |
| Width | 15.43b | 13.03c | 15.66b | 16.39ba | 15.45b | 16.15ba | 17.31a | ||
| BC5 | Length | 19.54ba | 21.39a | 19.75ba | 18.24ba | 20.31ba | 16.94b | 21.07a | |
| Width | 15.24ba | 15.87a | 15.22ba | 15.51ba | 16.62a | 13.15b | 15.56ba | ||
| BC7 | Length | 20.91b | 19.87b | n.d. | – | 19.26b | 24.70a | n.d. | |
| Width | 14.60b | 13.81b | 16.46b | 21.08a | |||||
| BC8 | Length | 19.13a | 20.35a | 20.53a | 20.58a | 20.92a | 19.09a | 16.75b | |
| Width | 15.82ba | 15.55ba | 16.06a | 15.30ba | 16.62a | 16.15a | 14.08b | ||
| BC9 | Length | 18.43bac | 17.85bc | 20.35a | 17.31c | 17.83bc | 19.92ba | 17.52bc | 18.09bac |
| Width | 14.34bc | 14.59bc | 15.09bac | 13.82c | 14.21bc | 16.21a | 13.77c | 15.42ba | |
| BC10 | Length | 17.36a | 17.45a | – | n.d. | – | 17.22a | 17.74a | n.d. |
| Width | 13.55a | 14.87a | 13.78a | 14.70a | |||||
| Isolate Code | Plant Host | Latin Name | Group | Transposable Element Type | ||||
|---|---|---|---|---|---|---|---|---|
| I | II | F | B | V | T | |||
| BC1 | Strawberry | Fragaria magna f. ananassa | + | + | ||||
| BC2 | Onion | Allium cepa | + | + | ||||
| BC3 | Tomato | Solanum lycopersicum | + | + | ||||
| BC4 | Raspberry | Rubus idaeus | + | + | ||||
| BC5 | Cabbage/leaf | Brassica oleracea | + | + | ||||
| BC6 | Apple | Malus domestica | + | + | ||||
| BC7 | Grapevine | Vitis spp. | + | + | ||||
| BC8 | Bell pepper | Capsicum annuum | + | + | ||||
| BC9 | Leek | Allium porrum | + | + | ||||
| BC10 | Rose | Rosa spp. | + | + | ||||
| Total | 1 | 9 | 1 | 1 | 4 | 4 | ||
Publisher’s Note: MDPI stays neutral with regard to jurisdictional claims in published maps and institutional affiliations. |
© 2021 by the authors. Licensee MDPI, Basel, Switzerland. This article is an open access article distributed under the terms and conditions of the Creative Commons Attribution (CC BY) license (https://creativecommons.org/licenses/by/4.0/).
Share and Cite
Dėnė, L.; Valiuškaitė, A. Sensitivity of Botrytis cinerea Isolates Complex to Plant Extracts. Molecules 2021, 26, 4595. https://doi.org/10.3390/molecules26154595
Dėnė L, Valiuškaitė A. Sensitivity of Botrytis cinerea Isolates Complex to Plant Extracts. Molecules. 2021; 26(15):4595. https://doi.org/10.3390/molecules26154595
Chicago/Turabian StyleDėnė, Lina, and Alma Valiuškaitė. 2021. "Sensitivity of Botrytis cinerea Isolates Complex to Plant Extracts" Molecules 26, no. 15: 4595. https://doi.org/10.3390/molecules26154595
APA StyleDėnė, L., & Valiuškaitė, A. (2021). Sensitivity of Botrytis cinerea Isolates Complex to Plant Extracts. Molecules, 26(15), 4595. https://doi.org/10.3390/molecules26154595






